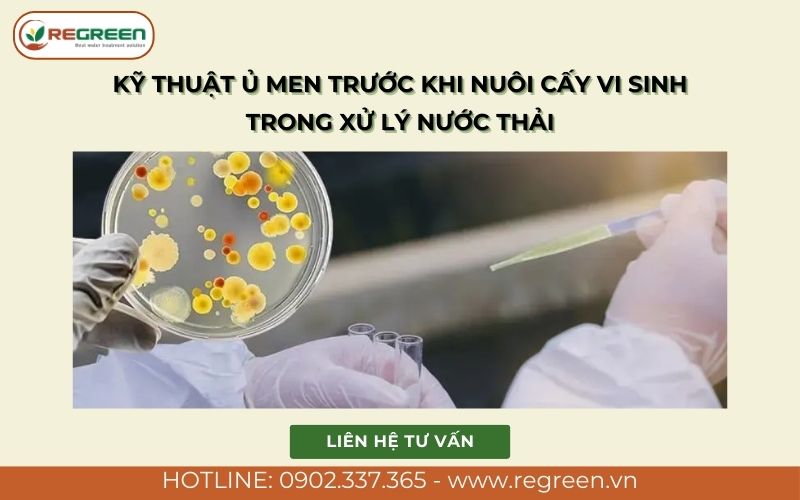
Kỹ thuật ủ men trước khi nuôi cấy vi sinh trong xử lý nước thải.

Trong các công nghệ xử lý nước thải hiện đại như AAO, Johkasou hay SBR, hệ vi sinh vật đóng vai trò như "trái tim" của cả hệ thống. Việc khởi động và duy trì hệ vi sinh khỏe mạnh là yếu tố tiên quyết để đảm bảo nước đầu ra đạt quy chuẩn QCVN. Tuy nhiên, thực tế vận hành cho thấy rất nhiều trạm xử lý gặp sự cố như bùn khó lắng, nổi bọt, chết vi sinh do áp dụng sai phương pháp nuôi cấy ngay từ đầu.
Là đơn vị chuyên tư vấn, thi công và cung cấp vật tư môi trường hàng đầu, Regreen Việt Nam thấu hiểu những khó khăn đó. Trong bài viết này, chúng tôi sẽ chia sẻ cách nuôi cấy vi sinh trong xử lý nước thải chi tiết từng bước, đúc kết từ kinh nghiệm thực chiến tại hàng trăm công trình, giúp bạn vận hành hệ thống ổn định và tiết kiệm chi phí nhất.
Điều kiện cần chuẩn bị trước khi thực hiện cách nuôi cấy vi sinh trong xử lý nước thải
Để quy trình nuôi cấy diễn ra thuận lợi, giảm thiểu rủi ro chết bùn, khâu chuẩn bị đóng vai trò quyết định đến 50% sự thành công. Trước khi đi vào cách nuôi cấy vi sinh trong xử lý nước thải cụ thể, bạn cần rà soát kỹ lưỡng 3 yếu tố sau:

Kiểm tra hệ thống thiết bị
Hệ thống cơ điện phải hoạt động trơn tru để tạo môi trường sống cho vi sinh vật:
- Hệ thống phân phối khí: Đảm bảo máy thổi khí và đĩa phân phối khí (các dòng sản phẩm chất lượng cao mà Regreen đang cung cấp) hoạt động ổn định. Oxy là sự sống của vi sinh hiếu khí, việc gián đoạn khí quá 4 giờ có thể khiến vi sinh chết hàng loạt.
- Hệ thống bơm: Kiểm tra bơm nạp nước thải và đặc biệt là bơm tuần hoàn bùn để duy trì nồng độ sinh khối trong bể.
- Giá thể vi sinh: Đối với các bể MBBR hay Aerotank cải tiến, việc lắp đặt giá thể vi sinh dạng cầu/tổ ong là cần thiết để tăng diện tích tiếp xúc, giúp vi sinh dính bám và phát triển mật độ cao hơn.
Chuẩn bị nguyên liệu nuôi cấy
Bạn cần chuẩn bị đầy đủ các nguồn dinh dưỡng và con giống:
- Men vi sinh: Lựa chọn các dòng men vi sinh xử lý nước thải chuyên dụng (dạng bột hoặc dạng lỏng) có hoạt lực cao, chứa đa chủng vi khuẩn Bacillus, Nitrosomonas, Nitrobacter... Regreen khuyến nghị sử dụng các dòng men nhập khẩu hoặc men vi sinh chất lượng cao do chúng tôi phân phối để rút ngắn thời gian khởi động.
- Chất dinh dưỡng:
- Nguồn Carbon: Mật rỉ đường (cung cấp năng lượng dễ hấp thụ).
- Nguồn Nitơ: Phân Ure.
- Nguồn Photpho: Phân lân (DAP).
Kiểm tra thông số đầu vào
Môi trường nước cần được tinh chỉnh về ngưỡng an toàn trước khi áp dụng cách nuôi cấy vi sinh trong xử lý nước thải:
- pH: Duy trì ổn định trong khoảng 6.5 – 8.5 (tối ưu nhất là 7.0 - 7.5). Nếu pH quá thấp hoặc quá cao, cần dùng hóa chất (như NaOH hoặc H2SO4/Vôi) để trung hòa.
- Nhiệt độ: Vi sinh phát triển tốt nhất ở 25 – 35 độ C.
- Chất độc hại: Đảm bảo nước thải không chứa nồng độ cao các chất diệt khuẩn (Clo dư, kim loại nặng, kháng sinh...) gây ức chế vi sinh.
Quy trình 4 bước cách nuôi cấy vi sinh trong xử lý nước thải hiệu quả nhất
Dưới đây là quy trình chuẩn mà các kỹ sư của Regreen Việt Nam thường áp dụng cho các trạm xử lý nước thải sinh hoạt và công nghiệp.
Bước 1: Giai đoạn kích hoạt (Ủ men)
Vi sinh vật ở dạng thương mại thường đang ở trạng thái ngủ đông (bào tử). Việc ủ men giúp chúng tỉnh lại và gia tăng sinh khối trước khi vào môi trường khắc nghiệt.
- Công thức pha: Hòa tan men vi sinh + Mật rỉ đường + Nước sạch theo tỷ lệ nhà sản xuất khuyến cáo (Thường là 1kg men : 1 lít mật rỉ : 10-20 lít nước sạch).
- Thời gian sục khí ủ: Sục khí nhẹ từ 2-4 tiếng (đối với vi sinh hiếu khí). Việc này giúp vi khuẩn kích hoạt enzyme trao đổi chất mạnh mẽ.
Bước 2: Khởi động hệ thống
- Bơm nước thải vào bể sinh học (Aerotank) khoảng 50-70% dung tích bể. Nếu nước thải quá đậm đặc (COD > 1000 mg/l), nên pha loãng với nước sạch để giảm tải lượng ban đầu.
- Đổ hỗn hợp men vi sinh đã ủ vào bể, vị trí đổ nên ở gần dòng nước vào hoặc đầu đĩa phân phối khí để men phân tán đều.
- Đây là bước cực kỳ quan trọng trong cách nuôi cấy vi sinh trong xử lý nước thải để tránh hiện tượng vi sinh bị sốc môi trường dẫn đến chết ngay lập tức.
Bước 3: Giai đoạn thích nghi (Acclimation)
Trong 1-3 ngày đầu tiên, mục tiêu là để vi sinh làm quen với thức ăn trong nước thải:
- Chạy máy thổi khí liên tục 24/24 nhưng chưa cấp thêm nước thải mới.
- Bổ sung dinh dưỡng hàng ngày để nuôi vi sinh phát triển. Cần tính toán liều lượng sao cho cân bằng tỉ lệ C:N:P trong xử lý nước thải (thường là 100:5:1).
- Quan sát sự hình thành của bùn hoạt tính (Activated Sludge). Lúc này, bùn bắt đầu kết thành các bông nhỏ li ti, màu nâu nhạt.
Bước 4: Nâng tải lượng và vận hành ổn định
Sau khi vi sinh đã thích nghi (thường sau 3-5 ngày), bắt đầu cho hệ thống ăn tải tăng dần:
- Ngày 3-5: Nạp nước thải mới với lưu lượng khoảng 30% công suất thiết kế.
- Ngày 5-10: Nếu nước đầu ra trong, tiếp tục tăng lên 50% -> 70% -> 100% công suất.
- Theo dõi chỉ số SV30: Lấy mẫu nước từ bể hiếu khí vào ống đong 1000ml, để lắng 30 phút. Nếu thể tích bùn lắng chiếm 200-300ml/L (20-30%) và nước phía trên trong, nghĩa là bạn đã thực hiện cách nuôi cấy vi sinh trong xử lý nước thải thành công.
Các yếu tố ảnh hưởng đến cách nuôi cấy vi sinh trong xử lý nước thải cần lưu ý
Để duy trì hệ thống ổn định lâu dài, người vận hành cần am hiểu sâu về các yếu tố kỹ thuật sau đây. Regreen luôn lưu ý khách hàng kiểm soát chặt chẽ các chỉ số này:

1. Nồng độ Oxy hòa tan (DO)
Đối với quy trình nuôi cấy vi sinh hiếu khí/kỵ khí, oxy là yếu tố sống còn. Trong bể Aerotank, nồng độ DO cần duy trì ở mức 2 - 4 mg/L.
- Nếu DO < 2 mg/L: Vi sinh hiếu khí sẽ bị ức chế, vi khuẩn dạng sợi phát triển gây hiện tượng bùn khó lắng (Bulking sludge).
- Nếu DO quá cao: Gây lãng phí điện năng và làm vỡ bông bùn, tạo ra bùn mịn trôi ra ngoài theo nước sau lắng.
- Giải pháp: Sử dụng máy thổi khí và đĩa thổi khí chất lượng từ Regreen để đảm bảo hiệu suất chuyển hóa oxy tốt nhất.
2. Chất dinh dưỡng (C:N:P)
Vi sinh vật cần thực đơn cân đối để phát triển tế bào. Tỷ lệ vàng trong xử lý nước thải hiếu khí là BOD:N:P = 100:5:1.
- Thiếu Nitơ/Photpho: Bùn sẽ bị tan, mịn, khó tạo bông, nước đầu ra đục.
- Thừa dinh dưỡng: Gây lãng phí và có thể gây phú dưỡng hóa nguồn tiếp nhận, làm tăng chỉ số đầu ra.
3. Tải lượng hữu cơ (F/M)
Tỷ lệ Thức ăn (Food) / Vi sinh vật (Microorganism) phải luôn cân bằng. Một sai lầm phổ biến trong cách nuôi cấy vi sinh trong xử lý nước thải là nạp tải quá lớn đột ngột (sốc tải).
- F/M cao (thừa thức ăn, thiếu vi sinh): Bùn phát triển nhanh nhưng khó lắng, oxy giảm nhanh.
- F/M thấp (thiếu thức ăn, thừa vi sinh): Vi sinh tự phân hủy nội bào, bùn già, nát vụn và nổi bọt nâu.
Dấu hiệu nhận biết cách nuôi cấy vi sinh trong xử lý nước thải thành công hay thất bại
Người vận hành giỏi là người biết "nhìn bùn đoán bệnh". Dưới đây là các dấu hiệu trực quan:
Dấu hiệu thành công:
- Màu sắc bùn: Bùn hiếu khí có màu nâu đất (màu socola), bùn kỵ khí có màu đen tuyền.
- Cấu trúc: Bông bùn to, kết cụm tốt, tốc độ lắng nhanh. Nước sau khi lắng 30 phút rất trong.
- Mùi: Nước đầu ra giảm hẳn mùi hôi thối đặc trưng của nước thải chưa xử lý.
Dấu hiệu sự cố & Cách khắc phục:
Trong quá trình vận hành, nếu gặp sự cố, bạn cần biết cách khắc phục sự cố vi sinh chết:
- Bùn nổi bọt trắng: Do vi sinh còn non hoặc bị quá tải. Khắc phục: Giảm lưu lượng nước thải vào, tăng cường sục khí.
- Bùn nổi bọt nâu, bọt váng dầu: Do vi sinh già, chết hoặc bể chứa nhiều dầu mỡ. Khắc phục: Xả bớt bùn dư, kiểm tra bể tách mỡ, bổ sung thêm men vi sinh mới.
- Mùi hôi nồng nặc, bùn chuyển đen trong bể hiếu khí: Do thiếu khí trầm trọng. Khắc phục: Kiểm tra ngay hệ thống máy thổi khí, đĩa khí xem có bị nghẹt hay hỏng hóc không.
Tại sao nên chọn vật tư và giải pháp từ Regreen Việt Nam cho cách nuôi cấy vi sinh trong xử lý nước thải?

Việc áp dụng cách nuôi cấy vi sinh trong xử lý nước thải đòi hỏi sự đồng bộ từ con giống, dinh dưỡng đến thiết bị. Regreen Việt Nam tự hào là đối tác tin cậy cung cấp giải pháp toàn diện:
- Sản phẩm chất lượng cao: Chúng tôi cung cấp các dòng men vi sinh hoạt lực mạnh, thích nghi tốt với nhiều loại nước thải (dệt nhuộm, sinh hoạt, chăn nuôi...). Bên cạnh đó là mật rỉ đường chuẩn, giá thể vi sinh dạng cầu/tổ ong với diện tích bề mặt lớn nhất thị trường.
- Thiết bị hiện đại: Regreen phân phối chính hãng các loại máy thổi khí (Longtech, Heywel...), bơm chìm, máy khuấy, đảm bảo hệ thống vận hành bền bỉ 24/7.
- Hỗ trợ kỹ thuật chuyên sâu: Không chỉ bán sản phẩm, đội ngũ kỹ sư môi trường của Regreen sẵn sàng tư vấn cách nuôi cấy vi sinh trong xử lý nước thải miễn phí, hỗ trợ hướng dẫn vận hành từ xa hoặc trực tiếp tại công trình cho khách hàng.
Thực hiện đúng cách nuôi cấy vi sinh trong xử lý nước thải không chỉ giúp hệ thống vận hành trơn tru, đạt chuẩn xả thải mà còn giúp doanh nghiệp tiết kiệm hàng chục triệu đồng chi phí xử lý sự cố hàng năm. Quy trình này đòi hỏi sự kiên nhẫn, tỉ mỉ và kiến thức chuyên môn vững vàng.
Hy vọng với hướng dẫn chi tiết trên đây, bạn đã nắm vững quy trình nuôi cấy vi sinh chuẩn kỹ thuật. Nếu bạn đang cần tìm kiếm nguồn men vi sinh chất lượng, giá thể vi sinh hay các thiết bị máy thổi khí chính hãng, hãy để Regreen Việt Nam đồng hành cùng bạn.
Liên hệ ngay Hotline/Zalo để được tư vấn, báo giá men vi sinh ưu đãi và nhận quy trình nuôi cấy miễn phí dành riêng cho hệ thống của bạn ngay hôm nay!
THÔNG TIN LIÊN HỆ:
- Trụ sở: 63/21C Đường số 9, P. Thủ Đức, Thành phố Hồ Chí Minh.
- Xưởng sản xuất: Đường - 768, Trảng Dài, Biên Hòa, Đồng Nai, Việt Nam.
- Điện thoại: 0902.337.365 – 0946.442.233.
- Form đăng ký: Điền form liên hệ tại đây.
- Email: [email protected] – [email protected].
- Website: www.regreen.vn
Câu hỏi thường gặp về cách nuôi cấy vi sinh trong xử lý nước thải
Để giúp bạn đọc hiểu rõ hơn, Regreen xin giải đáp các thắc mắc phổ biến nhất:
1. Thời gian nuôi cấy vi sinh mất bao lâu?
Trả lời: Thông thường, quy trình khởi động hệ thống mất từ 15 - 21 ngày để đạt trạng thái ổn định hoàn toàn và full tải. Tuy nhiên, nếu sử dụng men vi sinh chất lượng cao từ Regreen kết hợp với việc bổ sung giá thể, thời gian có thể rút ngắn xuống còn 10-14 ngày.
2. Làm sao biết vi sinh bị chết?
Trả lời: Các dấu hiệu điển hình bao gồm: Bùn trong bể hiếu khí chuyển từ màu nâu sang màu xám đen hoặc đen; Nước trở nên đục ngầu; Mùi hôi thối bốc lên nồng nặc; Chỉ số SV30 giảm mạnh, bùn không lắng được mà trôi theo nước ra ngoài.
3. Có cần bổ sung men vi sinh định kỳ không?
Trả lời: Có. Mặc dù vi sinh có khả năng tự sinh sản, nhưng trong quá trình vận hành sẽ có một lượng bị rửa trôi hoặc chết do biến động tải lượng. Việc bổ sung men định kỳ (ví dụ 1-2 tuần/lần với liều lượng nhỏ) giúp duy trì mật độ vi sinh ổn định và tăng cường hiệu quả xử lý, đặc biệt là khả năng xử lý Nitơ, Amoni.
4. Tỉ lệ pha mật rỉ đường khi nuôi cấy là bao nhiêu?
Trả lời: Tỉ lệ phổ biến nhất khi kích hoạt men là 1 lít mật rỉ đường + 1 kg (hoặc lít) vi sinh + 10-20 lít nước sạch. Tuy nhiên, trong quá trình nuôi cấy, lượng mật rỉ đường cần bổ sung vào bể sẽ phụ thuộc vào nồng độ COD/BOD trong nước thải đầu vào. Nếu nước thải nghèo dinh dưỡng (như nước thải sinh hoạt loãng), cần bổ sung nhiều hơn để đảm bảo tỉ lệ C:N:P.


